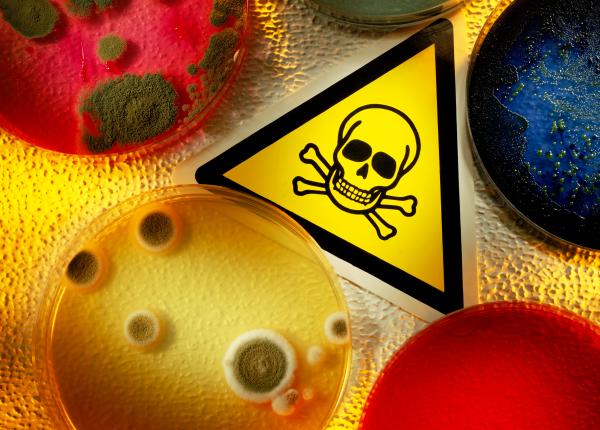
alergenul anului 2024 pericolul ascuns in mancarea si produsele pe care le consumam zilnic alergenul anului 2024 pericolul ascuns in mancarea si produsele pe care le consumam zilnic

Farma
Farma Forum: prima ediție a unei dezbateri profesionale organizată de Asociaţia Farmaciilor şi Farmaciştilor din România
Farma Forum 2024. Bogdan Chiriac, președinte AFFR: Profesia de farmacist este mai mult decât un simplu loc de muncă. Este o chemare profundă către îngrijirea și sănătatea oamenilor
Medicamentul pentru diabet care are efect asupra inimii. Reduce simptomele insuficienței cardiace, ajută la scăderea în greutate
CMSR solicită eliminarea discriminărilor privind tratarea pacienților aflați în situații de urgență
Prima terapie pentru tulburarea de stres post-traumatic, în aprobare. Cum funcționează tratamentul
Prima terapie asistată pentru tulburarea de stres post-traumatic ar putea fi aprobată.
Știrile zilei în sănătate: Medicamentul acuzat că ar crește riscul de cancer de colon
Știrile zilei în sănătate. Ce se întâmplă în lumea medicală mondială azi, 3 mai.
Ce să nu bei niciodată când iei antibiotic. Medic: Oamenii trebuie să știe! Nu este recomandat nici să stai la soare după ce ai luat antibiotic
De ce este recomandat să evităm consumul de lapte, iaurt, ceai sau suc de citrice în timpul administrării antibioticelor.
Știrile zilei în sănătate. Medicamentul pentru boala Huntington primește aprobarea FDA
Ce se întâmplă în lumea medicală azi, 1 mai 2024.
Vaccinul pentru cancerul de piele, în teste. Recunoaște și elimină toate celulele canceroase
Terapia pentru cancerul de vezică, aprobată. Activează celulele care luptă împotriva tumorilor
Știrile zilei în sănătate: Avertisment privind "drogul zombi". UE aprobă planul Illumina de a ceda Grail, producătorul de teste pentru cancer. ONU afirmă că bolile transmise prin apă se răspândesc
Ce se întâmplă azi, 13 aprilie, în lumea medicală mondială. Cele mai importante știri din sănătate.
Primele imagini din creier, văzute cu cel mai puternic RMN din lume - FOTO spectaculoase. Premieră mondială pentru boli precum Alzheimer și Parkinson
Premieră mondială: creierul, dezvăluit ca niciodată până acum datorită celui mai puternic RMN din lume proiectat și dezvoltat la CEA.
Novartis începe oferta de cumpărare pentru MorphoSys, companie axată pe cancer, pentru 2,7 miliarde de euro
Sistemul european pentru verificarea medicamentelor – o platformă implementată cu succes care ar putea fi extinsă pentru a răspunde unor noi provocări de sănătate
EXCLUSIV De ce nu avem acces la tratamente moderne. Prof. dr. Alexandru Rafila: Trebuie să existe resursă financiară pentru acest lucru
Tratamentele inovative ajung în România cu un decalaj semnificativ. Cum sunt, de fapt, afectați pacienții de aceste decalaje.
Vertex Pharma cumpără Alpine Immune cu 4,9 miliarde de dolari. Tratamentul revoluționar pe care-l va avea și care poate trata boli de rinichi și boala celulelor secerătoare
Vertex Pharma cumpără Alpine Immune cu 4,9 miliarde de dolari. Tratamenele revoluționare la care va avea acces și bolile pe care le pot trata.
Servicii decontate pentru neasiguraţi, în Planul Naţional de Cancer, de la 1 iulie. Valeria Herdea (CNAS): E un drept constituţional într-o astfel de boală. Nu e normal să moară atâţia oameni
La zi, în medicină. FDA refuză medicamentul pentru Parkinson. Un vaccin arată beneficii în cancerul de cap și gât. Concedieri masive într-o mare companie farma
Ce se întâmplă în medicină azi, 10 aprilie. Cele mai noi știri din domeniul sănătății.
EXCLUSIV Terapie inovatoare pentru cardiomiopatia hipertrofică obstructivă. Dr. Ioana Bianchi: Este disponibil
La zi, în medicină. Mitsui și Rohto vor cumpăra compania chineză de medicamente Eu Yan Sang, în valoare de 594 de milioane de dolari
Ce se întâmplă azi, 5 aprilie, în lumea medicală mondială. Decizii importante în industria farmaceutică.
EXCLUSIV Tratamentul pentru episoadele maniacale, reaprobat. Gabriel Diaconu: Nu e un tratament revoluționar. Nu îl avem în Europa. Noi avem altceva, dar face cam același lucru
La zi, în medicină. Dispozitivul de reparare a valvelor cardiace obține aprobarea FDA. Un medicament antiinflamator are rezultate promițătoare
Cine nu ar trebui să ia antiinflamatoare. Pot duce la hipertensiune, hemoragii digestive sau cerebrale
Medicamentul pentru menopauză, victorie în studiile clinice avansate. Reduce simptomele menopauzei. Se cere aprobarea lui
Medicamentul Bayer pentru menopauză și-a atins obiectivul cheie în cadrul unui studiu în fază avansată.
AstraZeneca va cumpăra compania biofarmaceutică Fusion Pharmaceuticals pentru 2 milioane de dolari în numerar
AstraZeneca a anunțat că va cumpăra compania biofarmaceutică Fusion Pharmaceuticals, pentru aproximativ 2 miliarde de dolari în numerar
Ketamina, pe primul loc în București la substanțele recreative folosite ilegal. Dr Radu Țincu, după declarația lui Elon Musk: Mi se pare extrem de grav! Va produce un efect major
CDC îndeamnă la vaccinarea împotriva rujeolei. Prima terapie genică pentru copiii cu boli genetice rare, aprobată în SUA. Știrile zilei în lumea medicală
Știrile zilei în lumea medicală. Ce se întâmplă în lume azi, 19 martie.
Sulfiții, numiți "alergenul anului" 2024. Riscul ascuns din alimente, haine, machiaje și produse pe care le folosim zilnic
Sulfiții au fost numiți drept alergenul anului 2024. Ce sunt sulfiții și unde îi găsim. Suntem expuși la ei mai mult decât credeam.
Noi tratamente pentru cancerul de col uterin și cancerul de sânge și un nou rival al Ozempic. 10 știri importante din lumea medicală: 16 martie
AstraZeneca va cumpăra Amolyt Pharma pentru a mări portofoliul de boli rare
AstraZeneca va cumpăra Amolyt Pharma pentru 1,05 miliarde de dolari pentru a mări portofoliul de boli rare.
Ce se întâmplă azi, 14 martie, în lumea medicală. Cât de eficient este vaccinul anti-HPV. Care terapii împotriva cancerului sunt investigate de FDA
Medicamentul cu rezultate foarte bune împotriva cancerului de sânge. Are succes într-un studiu în fază avansată
Un nou medicament oferă rezultate foarte bune împotriva cancerului de sânge.
FDA refuză să aprobe injecția pentru scleroza multiplă
FDA din SUA refuză să aprobe o injecție pentru scleroza multiplă.
FDA intensifică inspecțiile la producătorii de medicamente din India. De ce s-a luat această decizie
Producția de medicamente din India va fi din ce în ce mai urmărită de FDA. De ce s-a luat această decizie.
Suven Pharma din India, Suven Pharma și Cohance fuzionează pentru stimularea serviciilor de fabricare a medicamentelor
Suven Pharma din India, Suven Pharma și Cohance fuzionează pentru a stimula serviciile de fabricare a medicamentelor pe bază de contract.
EXCLUSIV Legătura dintre anticoncepționale și tromboza venoasă profundă. Dr. Niculescu: Cea mai frecventă cauză printre pacientele noastre tinere
De ce tromboza venoasă profundă este o amenințare ascunsă pentru femeile care iau anticoncepționale.
Medicamentul care devine periculos odată cu înaintarea în vârstă. Este frecvent folosit. Provoacă insuficiență renală
Pseudoefedrina, substanța din medicamente care provoacă AVC. EMA, avertisment. Adrian Marinescu: Trebuie să existe atenție
Marea greșeală pe care o facem cu antibioticul. Marinescu: Sunt frecție la picior de lemn! Ne punem probleme de vaccin, dar luăm antibiotice care au reacții adverse. Le luăm ca pe bomboane
Antibioticele, la liber, sub incidența Codului Penal. Pot fi eliberate în regim de urgență, fără prescriptie medicală, pentru 72 de ore
Cum să scapi de răceală în 24 de ore. Un farmacist a dezvăluit secretul: Asta e cheia pentru a vă însănătoși
Cum să scapi de răceală în 24 de ore. Un farmacist a dezvăluit secretul: Vitamina C nu e de prea mare ajutor.
De ce să nu mai combini niciodată Paracetamol, ibuprofen și aspirină. Dr. Marinescu: Atenție! Nu ai de ce să le amesteci. O răceală banală nu are nevoie de nimic
Ce s-a aflat despre medicamentele pentru diabet care ajută și la slăbire. Efectul dramatic pe care îl au asupra creierului
Ce s-a aflat despre medicamentele pentru diabet care ajută și la slăbire. Au un efect dramatic asupra creierului.
Suplimentele de magneziu: tot ce trebuie să știi înainte să le iei
Suplimentele de magneziu sunt un ajutor pentru anxietate. Funcționează?
Alimentele pe care nu trebuie să le consumi când iei anumite medicamente. Pot anula efectul tratamentului sau chiar să provoace mai mult rău
EXCLUSIV Greșeala mortală pe care o facem când suntem răciți. Adrian Marinescu: Le luăm ca pe bomboane
O greșeală pe care o facem când suntem răciți ne poate agrava situația. Mai mult, poate duce și la alte complicații, unele cu potențial mortal.
Anticonvulsivele, efecte letale. Afectează inima, rinichii și plămânii și pot duce la deces. Sunt prescrise și la noi în țară
EXCLUSIV Antibioticele, eliberate la discreție. Anca Crupariu: Ne duce cu gândul că a existat o presiune asupra medicului
EXCLUSIV Antibioticele, prescrise sub presiunea pacienților. Gindrovel Dumitra: Depinde de fiecare dintre noi să rezistăm acestor presiuni. Categoric nu este recomandat
-
-
-
-
Regula 20-20-20: Trucul recomandat de oftalmologi pentru ochii obosiți
13 mai 2026, 17:03 -